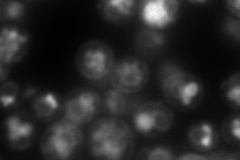
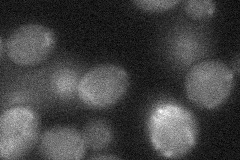

View description
Flavin-linked sulfhydryl oxidase localized to the endoplasmic reticulum lumen, involved in disulfide bond formation within the ER
Localization:
Intensity:
Fold change:
Significance:
-
C’ GFP library in SD

below threshold14.8 -
N' NOP1pr-GFP in SD

punctate,vacuole,vacuole membrane109.245 -
N' TEF2pr-mCherry in SD
ER,vacuole280.46 -
N' NATIVEpr-GFP in SD

punctate24.8038 -
N' TEF2pr-VC and Cyto-VN in SD
below threshold24.8294 -
C’ GFP library in SD+DTT

cytosol16.431.1No -
C’ GFP library in SD+H2O2

cytosol18.141.22No -
C’ GFP library in Starvation Media

cytosol15.531.04No -
C’ GFP library on the background of Pup2-DaMP

below threshold -
C’ GFP library on the background of CCT mutant

below threshold15.76831.06495No
